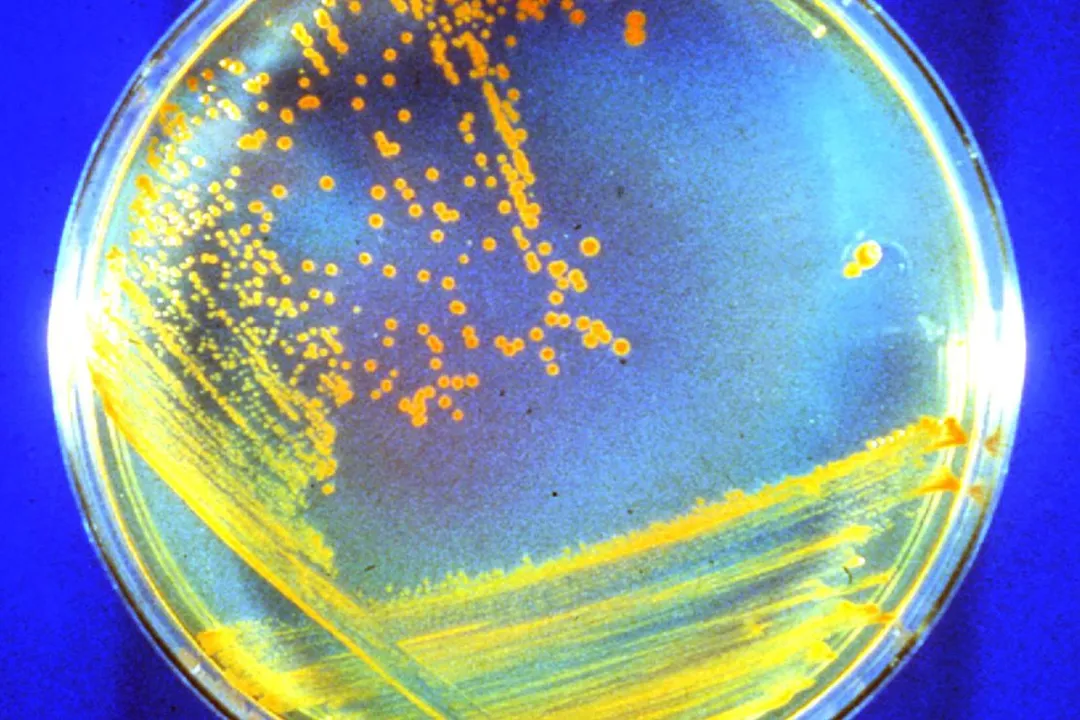
Did we find dead bacteria on Mars?
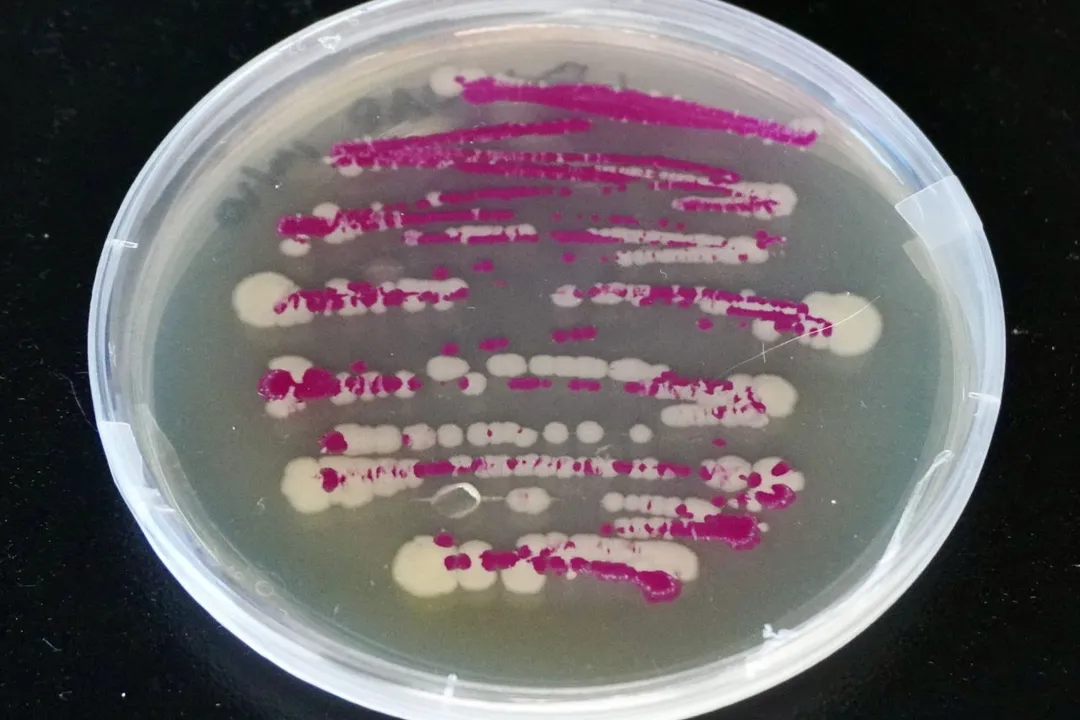
Did we find dead bacteria on Mars?, Subsurface History

Did we find dead bacteria on Mars?
The ongoing quest to determine if life—even ancient, extinct life—ever existed on Mars has recently entered a fascinating, yet cautious, new phase. While the definitive discovery of Martian microbes, dead or alive, remains elusive, instruments on the ground have gathered data suggesting that the ingredients and structures associated with past life are present in the planet's rocks. The focus right now is less on seeing intact, fossilized bacteria and more on identifying chemical or structural biosignatures that Earth-based life leaves behind.
This investigation is challenging not just because of the vast distance and the harsh Martian environment, but because of the complex protocols required to ensure we aren't simply finding evidence of contamination from our own planet. Every potential finding needs rigorous confirmation, often requiring samples to be returned to Earth for analysis that current rovers simply cannot perform.
# Rock Signatures

The most compelling modern evidence stems from NASA's Perseverance rover, which has been exploring Jezero Crater, an ancient lakebed environment. This location was chosen precisely because water existed there billions of years ago, providing the necessary conditions for life as we know it to potentially arise. The rover's instruments have analyzed Martian rock cores, identifying organic molecules and textures that warrant further investigation.
It is important to distinguish between finding organic molecules—the building blocks of life—and finding actual evidence of life itself. Many non-biological, or abiotic, geological processes can create organic compounds on Mars. What scientists are looking for are complex patterns that suggest biological activity shaped the material, rather than simple chemical reactions. For instance, finding organized structures that resemble microfossils, or the specific chemical ratios indicative of biological processes, carries far more weight than a simple detection of carbon.
When assessing these potential biosignatures, we can mentally organize the evidence into tiers of confidence, which helps contextualize the current scientific stage:
| Evidence Type | Description | Confirmation Level |
|---|---|---|
| Organic Molecules | Simple carbon compounds detected by onboard instruments. | Low (Can be produced abiotically) |
| Texture/Morphology | Rock structures resembling the vestiges of cells or microbial mats. | Medium (Requires high-resolution microscopy) |
| Isotopic Ratios | Specific ratios of light/heavy elements suggesting biological processing. | High (Requires Earth-based lab analysis) |
Currently, the findings from Perseverance sit primarily in the first two tiers—exciting hints that necessitate the final, highest tier of confirmation through sample return. The goal of the current mission phase is selecting the best targets that maximize the chance of finding definitive proof when those rocks eventually make it back home.
# Subsurface History
If Mars once hosted life, the evidence for it is likely buried deep beneath the surface. Mars today is cold, dry, and exposed to intense radiation, making surface survival for known life forms impossible. However, billions of years ago, the environment was much warmer and wetter. Evidence suggests that life, if it ever took hold, would have likely retreated underground as the planet dried out.
This subsurface migration is a key concept in Martian astrobiology. Deep within the crust or protected by subsurface ice deposits, life might have persisted long after the surface became uninhabitable. Therefore, the dead bacteria we might find are almost certainly not recently deceased; they would be ancient fossils, perhaps entombed in minerals that formed around them as water evaporated or ice sublimated.
A scenario frequently discussed involves deep-dwelling microbes surviving near geothermal heat sources or utilizing subsurface ice as a water source. If such life existed, the rocks currently being drilled by Perseverance represent the remnants of that habitable zone, now exposed by erosion or excavation. These ancient remains would be snapshots of a different era, showing us how life began or adapted on another world, assuming it did so independently of Earth. This deep history gives researchers hope that even if surface life failed early, subterranean ecosystems might have provided a longer-lasting refuge.
# Terrestrial Risk

The human element in space exploration brings a critical challenge: preventing forward contamination. Every spacecraft sent to another world is assembled in highly specialized "clean rooms" on Earth, yet keeping these environments perfectly sterile is nearly impossible. Microorganisms native to Earth, including resilient bacteria and fungal spores, can adhere to equipment and survive the launch, transit, and landing on Mars.
This presents a genuine scientific dilemma: how can we be certain that a detected biosignature wasn't simply hitchhiked from the assembly facility?. For example, certain types of bacteria can enter a dormant, highly resistant state, allowing them to endure extreme conditions, including radiation and vacuum, for extended periods. If scientists detected a complex organic structure on Mars that looked suspiciously like a common Earth contaminant bacterium, it would throw the entire finding into doubt.
This is why the Planetary Protection protocols are so stringent. Missions must minimize bioburden, and any potential discovery must undergo a multi-stage verification process that specifically looks for signs of terrestrial origin. Scientists must confirm that any detected life is chemically and structurally alien to Earth life, or prove that the material could not have been transported from our planet. The very robustness of Earth microbes means that their accidental presence is a constant shadow cast over Mars sample analysis.
# Future Analysis

The current results from the rover missions are foundational but preliminary. The next major step involves caching these carefully selected rock cores for a future sample return mission. Only by bringing these materials back to sophisticated laboratories on Earth can researchers perform the detailed chemical and isotopic analysis necessary to move beyond "potential biosignatures" to confirmed evidence of past Martian life.
For instance, confirming the presence of extinct life relies heavily on determining the carbon isotope ratios within the organic material. Terrestrial life has a strong preference for the lighter isotope, Carbon-12, during metabolic processes. If Martian samples show a statistically significant enrichment of Carbon-12 compared to the local geology, it would strongly suggest biological activity occurred. This type of precise measurement requires instruments far more sensitive than those that can be miniaturized and sent on a rover.
Considering the implications of a confirmed find, even of dead bacteria, it forces us to confront the possibility of life arising independently twice in one solar system. One insight that arises from this separation is the challenge of interpretation: Martian life might not follow the same chemical rules as Earth life. If Martian organisms utilized elements or molecular structures completely unknown on our home world, current detection methods might easily overlook them, even if the samples were here on Earth. Researchers must keep an open mind, designing experiments that look for any organized complexity, not just structures that mimic terrestrial cell biology.
This search also underscores the importance of in situ analysis even when samples are slated for return. The rover acts as the first filter, identifying the most promising geological contexts—like ancient mudstones or hydrothermal veins—that had the greatest potential to preserve evidence over aeons. Successfully navigating the contamination hurdles and collecting these pristine core samples represents a significant technical achievement, paving the way for what could be one of humanity's most profound scientific discoveries.
#Videos
What We Just Found on Mars - YouTube
Related Questions
#Citations
Evidence for Microbial Life on Mars: Fossilized Bacteria? | AMNH
NASA Says Mars Rover Discovered Potential Biosignature Last Year
NASA discovered a bacteria that can 'play dead' - National Geographic
If we found microbial life on Mars that was guaranteed to have ...
The bacteria that won't wake up: NASA discovers new ... - UF News
Life on Mars - Wikipedia
Ancient microbes may have survived below Mars' surface - CNN
What We Just Found on Mars - YouTube
New study says microbes on Mars might be living in the ice - EarthSky
NASA: Perseverance found possible biosignatures in Martian rock
